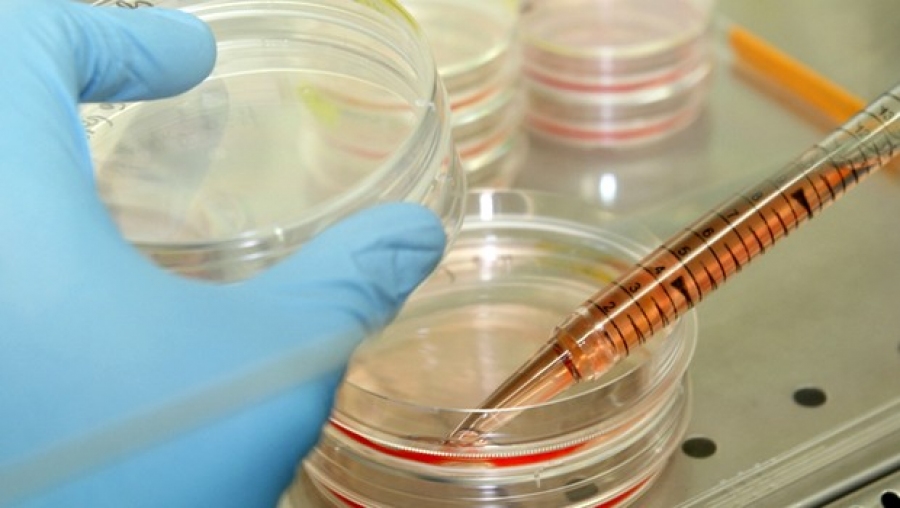
Cancer du pancréas

Des chercheurs britanniques sont arrivés à une étude sur le cancer du pancréas qui offre l'espoir d'un dépistage précoce à cette maladie.Selon une étude publiée lundi aux Etats-Unis, des niveaux élevés d'une combinaison de trois protéines trouvées dans l'urine peuvent permettre de détecter des cancers du pancréas peu avancés avec plus de 90% d'exactitude Mais il n'existe pour l'instant aucun test pour dépister précocement cette tumeur.Cette découverte pourrait ouvrir la voie à un dépistage non-invasif et peu coûteux de personnes considérées à haut risque de développer ce cancer très agressif, dont les symptômes se manifestent le plus souvent quand il est déjà très avancé et qu'une intervention chirurgicale n'est plus utile, selon les auteurs dont les travaux paraissent dans la revue Clinical Research.L'équipe de recherche du Barts Cancer Institute, de l'Université Queen Mary à Londres, a analysé des échantillons d'urine provenant de 488 personnes, dont 192 déjà diagnostiquées d'un cancer du pancréas, 92 atteintes de pancréatite et 87 étaient en bonne santé.En outre, les chercheurs ont analysé 117 autres échantillons d'urine de patients souffrant d'autres pathologies hépatiques bénignes ou d'un cancer du foie ainsi que de problèmes de vésicule biliaire.Les urines analysées contenaient environ 1.500 protéines. Sur ce total, trois protéines, appelées LYVE1, REG1A et TFF1, ont été retenues pour être davantage étudiées.Bien qu'il n'y ait pas de cause universelle connue du cancer du pancréas, les personnes considérées comme ayant un plus grand risque ont des antécédents familiaux de la maladie, sont de gros fumeurs, souffrent d'obésité ou sont devenues diabétiques après 50 ans.
-
Votre commentaire
Votre commentaire s'affichera sur cette page après validation par l'administrateur.
Ceci n'est en aucun cas un formulaire à l'adresse du sujet évoqué,
mais juste un espace d'opinion et d'échange d'idées dans le respect.
Posté par : presse-algerie
Ecrit par : Algérie Presse Service
Source : www.aps.dz